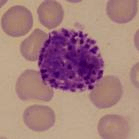

Anatomía Humana
apuntes
-
2º parcial anatomía
He publicado nuevos apuntes de 1º Anatomía Humana: 2º parcial anatomía
He publicado nuevos apuntes de 1º Anatomía Humana: Tema-1.-Articulaciones.pdf
apuntes
-
Primer parcial T1-T21
He publicado nuevos apuntes de 1º Anatomía Humana: Primer parcial T1-T21
Apuntes sobre Examen teórico del carnet de conducir. Lo más importante esquematizadlo para estudiar
He publicado nuevos apuntes de 1º Anatomía Humana: wuolah-app-2026-02-10-09-09-07.pdf.pdf
Repaso cosas importantes, músculos, huesos, articulaciones…agrupadas para tener una idea de todo
Exámenes por temas del 2º parcial de anatomía (respuestas debajo de cada tema)
He publicado nuevos apuntes de 1º Anatomía Humana: netter-faringe-fauces....pdf
apuntes
-
Primer parcial
He publicado nuevos apuntes de 1º Anatomía Humana: Primer parcial
He publicado nuevos apuntes de 1º Anatomía Humana: Musculatura-raquidea-y-toracica.pdf
apuntes
-
Anatomía 1e Parcial - Muy bueno
He publicado nuevos apuntes de 1º Anatomía Humana: Anatomía 1e Parcial - Muy bueno
He publicado nuevos apuntes de 1º Anatomía Humana: Seminario-3-Anatomia.pdf
He publicado nuevos apuntes de 1º Anatomía Humana: Seminario-Anato6-1.pdf
He publicado nuevos apuntes de 1º Anatomía Humana: Seminario-Anato5-1.pdf
He publicado nuevos apuntes de 1º Anatomía Humana: Seminario-1-Anatomia.pdf
He publicado nuevos apuntes de 1º Anatomía Humana: Seminario-Anatomia-1.pdf
He publicado nuevos apuntes de 1º Anatomía Humana: 2o-PARCIAL-ANATOMIA.pdf
He publicado nuevos apuntes de 1º Anatomía Humana: 1o-PARCIAL-ANATOMIA.pdf
apuntes
-
ANATOMÍA
He publicado nuevos apuntes de 1º Anatomía Humana: ANATOMÍA
apuntes
-
ESQUEMA SANGRE
imágenes y esquemas para estudiar sangre y linfa
examenes
-
Exámenes CON respuesta 2º parcial
He publicado nuevos examenes de 1º Anatomía Humana: Exámenes CON respuesta 2º parcial
examenes
-
Exámenes SIN respuesta 2º parcial
He publicado nuevos examenes de 1º Anatomía Humana: Exámenes SIN respuesta 2º parcial
He publicado nuevos apuntes de 1º Anatomía Humana: Netter-craneo-pdf.pdf
He publicado nuevos apuntes de 1º Anatomía Humana: Esquema-nervios-craneales.pdf
He publicado nuevos apuntes de 1º Anatomía Humana: Rinon-partes-anato.pdf
He publicado nuevos apuntes de 1º Anatomía Humana: Embriologia-T2-anato.pdf
He publicado nuevos apuntes de 1º Anatomía Humana: Nervios-espinales--construccion-nervio-espinal-anato.pdf
apuntes
-
Anatomía 2º Parcial
He publicado nuevos apuntes de 1º Anatomía Humana: Anatomía 2º Parcial
examenes
-
QUIZ PARA REPASAR
He publicado nuevos examenes de 1º Anatomía Humana: QUIZ PARA REPASAR
apuntes
-
APUNTES SEGUNDO PARCIAL ANATOMÍA
He publicado nuevos apuntes de 1º Anatomía Humana: APUNTES SEGUNDO PARCIAL ANATOMÍA
apuntes
-
APUNTES PRIMER PARCIAL ANATOMÍA
He publicado nuevos apuntes de 1º Anatomía Humana: APUNTES PRIMER PARCIAL ANATOMÍA
Recopilación preguntas de examen Primer parcial Anatomía Humana
He publicado nuevos apuntes de 1º Anatomía Humana: Atlas Prometheus: Anatomía General y aparato locomotor.pdf
He publicado nuevos apuntes de 1º Anatomía Humana: Anatomia-Estructuras-del-cuello-mamas-abdomen.pdf
He publicado nuevos examenes de 1º Anatomía Humana: examen-anatomia2oparcial.pdf
He publicado nuevos examenes de 1º Anatomía Humana: examen-anatomia1oparcial.pdf
He publicado nuevos examenes de 1º Anatomía Humana: Anatomia-2oParcial.pdf
He publicado nuevos apuntes de 1º Anatomía Humana: APUNTES-2o-parcial.pdf
apuntes
-
apuntes anatomia parcial 1
He publicado nuevos apuntes de 1º Anatomía Humana: apuntes anatomia parcial 1
He publicado nuevos apuntes de 1º Anatomía Humana: Apuntes-1o-parcial.pdf